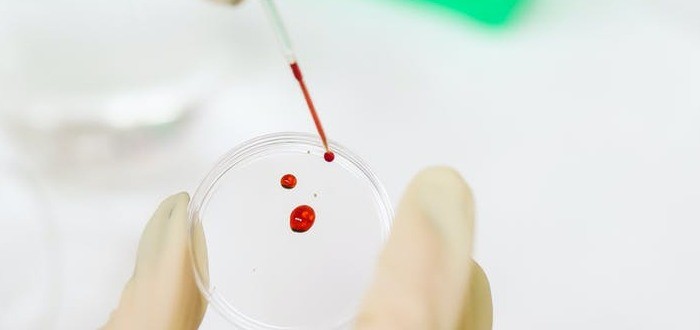
مما يتكون الدم

المحتويات
الدم ضروري للحياة ويدور عبر الجسم ويوصل المواد الأساسية مثل الأكسجين والمغذيات إلى خلايا الجسم ، كما أنه ينقل منتجات النفايات الأيضية بعيدًا عن تلك الخلايا نفسها ، لا يوجد بديل للدم لا يمكن صنعه ، الجهات المانحة السخية للدم هي المصدر الوحيد للدم للمرضى الذين يحتاجون إلى نقل الدم.
مكونات الدم
خلايا الدم الحمراءخلايا الدم الحمراء (RBC) تسمى أيضًا كريات الدم الحمراء ، تنقل الأكسجين من رئتيك إلى الأنسجة والأعضاء ، تموت خلايا الدم باستمرار ويصنع جسمك خلايا جديدة ، تعيش خلايا الدم الحمراء حوالي 120 يومًا ،خلايا الدم الحمراء هي النوع الأكثر شيوعًا لخلايا الدم والوسائل الرئيسية لكائن الفقاريات لتوصيل الأكسجين (O2) إلى أنسجة الجسم عن طريق تدفق الدم عبر الدورة الدموية ، إن سيتوبلازم كريات الدم الحمراء غنية بالهيموغلوبين ، وهو جزيء حيوي يحتوي على الحديد يمكنه ربط الأكسجين وهو مسؤول عن اللون الأحمر للخلايا ، إن أول أكسيد الكربون خطير للغاية لأنه يرتبط بقوة أكبر بهيموجلوبين الأكسجين.خلايا الدم البيضاءخلايا الدم البيضاء (WBCs) ، وتسمى أيضًا الكريات البيضاء هم أحد مكونات جهاز المناعة الذي يشارك في حماية الجسم ضد كل من الأمراض المعدية والغزاة الأجانب ، يتم إنتاج جميع خلايا الدم البيضاء واستخراجها من خلايا النخاع العظمي المعروفة بالخلايا الجذعية المكونة للدم ، تم العثور على الكريات البيض في جميع أنحاء الجسم ، بما في ذلك الدم والجهاز اللمفاوي ، تعيش بعض خلايا الدم البيضاء أقل من يوم واحد ، لكن البعض الآخر يعيش لفترة أطول ، تحتوي جميع خلايا الدم البيضاء على نويات تميزها عن خلايا الدم الأخرى ، مثل خلايا الدم الحمراء والصفائح الدموية.الفئات الرئيسية اثنين من خلايا الدم البيضاء المحببة و خلية غير محببة الخلايا الحبيبية هي فئة من خلايا الدم البيضاء تتميز بوجود حبيبات في السيتوبلازم.الخلايا المحببةالعدلات نوع من الخلايا المحببة هي الأكثر وفرة من جميع خلايا الدم البيضاء ، العدلات هي النوع الأكثر وفرة من الخلايا المحببة وأكثر أنواع وفرة (40 ٪ إلى 75 ٪) من خلايا الدم البيضاء في معظم الثدييات ، تشكل جزءًا أساسيًا من جهاز المناعة الفطري ، وتتكون من الخلايا الجذعية في نخاع العظام ، فهي قصيرة العمر ومتحركة للغاية ، أو متحركة ، حيث يمكنها دخول أجزاء من الأنسجة حيث لن تتمكن الخلايا / الجزيئات الأخرى من الدخول بخلاف ذلك. خلال المرحلة الأولى الحادة من الالتهاب ، خاصة نتيجة للعدوى البكتيرية والتعرض البيئي وبعض أنواع السرطان ، تعد العدلات من أوائل المستجيبين للخلايا الالتهابية للهجرة نحو موقع الالتهاب ، إنها الخلايا السائدة في القيح.الحمضاتالحمضات هي نوع من خلايا الدم البيضاء وأحد مكونات جهاز المناعة المسؤولة عن مكافحة الطفيليات متعددة الخلايا وبعض العدوى في الفقاريات ، إلى جانب الخلايا البدينة ، تتحكم أيضًا في الآليات المرتبطة بالحساسية والربو ، وهي خلايا حبيبية تتطور أثناء تكون الدم في النخاع العظمي قبل الهجرة إلى الدم.الخلية البدينةعلى الرغم من أنها معروفة بدورها في الحساسية والتأق ، تلعب الخلايا البدينة دورًا وقائيًا مهمًا أيضًا ، حيث تشارك بشكل وثيق في التئام الجروح ، وتولد الأوعية ، والتسامح المناعي ، والدفاع ضد مسببات الأمراض ، ووظيفة الحاجز الدموي الدماغي ، تشبه الخلايا البدينة الخلايا الحبيبية القاعدية (فئة من خلايا الدم البيضاء) في الدم ، كلاهما عبارة عن خلايا حبيبية تحتوي على الهستامين والهيبارين ، وهو مضاد للتخثر ، تطلق كلا الخليتين أيضًا الهيستامين عند الارتباط بالجلوبيولين المناعي E.خلايا قاعديةالخلايا القاعدية هي نوع من خلايا الدم البيضاء ، الخلايا القاعدية هي الأقل شيوعًا في الخلايا الحبيبية ، حيث تمثل حوالي 0.5 إلى 1 ٪ من خلايا الدم البيضاء المتداولة ، ومع ذلك ، فهي أكبر نوع من الخلايا الحبيبية ، وهي مسؤولة عن التفاعلات الالتهابية أثناء الاستجابة المناعية ، وكذلك في تكوين أمراض الحساسية الحادة والمزمنة ، بما في ذلك الحساسية المفرطة والربو والتهاب الجلد التأتبي وحمى القش. يمكنهم إجراء البلعمة أكل الخلايا، وإنتاج الهيستامين والسيروتونين الذي يسبب الالتهاب ، والهيبارين الذي يمنع تخثر الدم.الخلايا المحببةالخلايا Agranulocytes ، والمعروفة أيضًا باسم الكريات البيض أحادية النواة ، هي خلايا دم بيضاء ذات نواة ذات فص واحد ، تتميز بعدم وجود حبيبات في السيتوبلازم ، مما يميزها عن الخلايا الحبيبية ، النوعان من الخلايا المحببة في الدورة الدموية هما اللمفاويات والخلايا الأحادية ، يتم تشكيل نوع ثالث من الخلايا المحببة البلاعم ، في الأنسجة عندما تغادر الخلايا الأحادية الدورة الدموية وتختلف في البلاعم.اللمفاوياتتشمل الخلايا الليمفاوية الخلايا القاتلة الطبيعية (خلايا NK) التي تعمل في المناعة الفطرية السامة للخلايا بوساطة الخلية ، والخلايا التائية المناعة التكيفية التي تتوسطها الخلايا ، والسامة للخلايا ، والخلايا B للمناعة التكيفية التي تحركها الأجسام المضادة للخلايا ، هم النوع الرئيسي من الخلايا الموجودة في اللمف ، والتي دفعت اسم اللمفاويات ، تشارك الخلايا التائية في المناعة الخلوية ، في حين أن الخلايا البائية هي المسؤولة في المقام الأول عن المناعة الخلطية المتعلقة بالأجسام المضادة ، تتمثل وظيفة الخلايا التائية والخلايا B في التعرف على مستضدات غير ذاتية معينة ، خلال عملية تعرف باسم عرض المستضد.الوحيداتهم أكبر نوع من الكريات البيض ويمكن أن يفرقوا في الخلايا الضامة أو الخلايا التغصنية ، كجزء من الفقاريات الفطرية في الجهاز المناعي الفطري تؤثر أيضًا على عملية المناعة التكيفية الوحيدات تكون أمينية الشكل في المظهر ، ولها سيتوبلازم حبيبي.البلاعمالبلاعم هي نوع من خلايا الدم البيضاء التي تبتلع وتهضم الحطام الخلوي والمواد الغريبة والميكروبات والخلايا السرطانية وأي شيء آخر لا يحتوي على أنواع من البروتينات الخاصة بخلايا الجسم السليمة على سطحها في عملية تسمى البلعمة ، تم العثور على هذه البالعات الكبيرة في جميع الأنسجة بشكل أساسي ، حيث تقوم بدوريات بحثًا عن مسببات الأمراض المحتملة عن طريق حركة الأميبات.الصفائحتساعد الصفائح الدموية على تجلط الدم عندما يكون لديك جروح ، النخاع العظمي ، المادة الإسفنجية داخل عظامك ، يصنع خلايا دم جديدة ، تعيش الصفائح الدموية حوالي 6 أيام مثل الخلايا الحمراء ، الصفائح الدموية ليس لها نواة ومع ذلك ، على عكس الخلايا الحمراء التي تنشأ في النخاع كخلايا ذات نواة وتفقد نواتها ، يتم إنتاج الصفائح الدموية من خلال انحيازها من خلية نخاع عملاقة متعددة النوى تسمى خلية ضخمة.بلازما الدم بلازما الدم هي مكون سائل بلون أصفر باهت من الدم يحمل خلايا الدم في الدم بالكامل في حالة تعليق ، وتشكل حوالي 55٪ من إجمالي حجم الدم في الجسم هو جزء من السائل داخل الأوعية الدموية من السائل خارج الخلية جميع سوائل الجسم خارج الخلايا ، غالبًا ما يكون الماء حتى 95٪ من حيث الحجم ، ويحتوي على بروتينات مذابة 6-8٪ مثل الألبومين في الدم ، الجلوبيولين ، والفيبرينوجين ، الجلوكوز ، عوامل التخثر ، الشوارد Na + ، Ca2 + ، Mg2 ، Cl ، والهرمونات ، وثاني أكسيد الكربون ، يعمل البلازما أيضًا كمخزون بروتين لجسم الإنسان ، يلعب دورًا حيويًا في التأثير التناضحي داخل الأوعية الدموية الذي يحافظ على الشوارد في شكل متوازن ويحمي الجسم من العدوى وأمراض الدم الأخرى.[1]